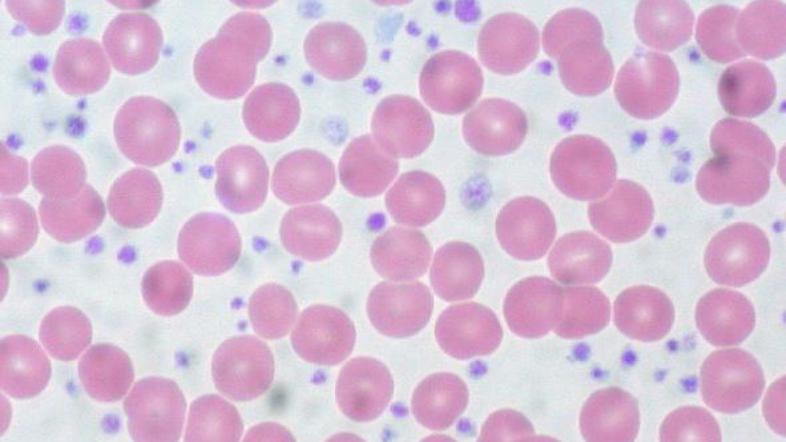
Trombozitoza

Krvne ploščice ali trombociti so krvne celice, ki imajo veliko vlogo pri strjevanju krvi, saj mašijo rane. Običajno je v kubičnem milimetru od 140 do 340 tisoč krvnih ploščic. Odstopanja od teh vrednosti se kažejo kot motnje oziroma nepravilnosti v strjevanju krvi.
Zmanjšano število trombocitov imenujemo trombocitopenija in je pogosta pri vnetjih in jetrnih bolnikih (cirozah). Povzroči jo lahko tudi okužba s HIV-om, virusom herpesa, jemanje določenih zdravil, nekatere revmatične in tudi avtoimunske bolezni.
Povečano število trombocitov je trombocitoza. Gre za redko bolezen oziroma napako v čezmernem proizvajanju krvnih ploščic, pri čemer obstaja veliko tveganje za nastanek krvnih strdkov in zapletov, kot sta možganska in srčna kap ali krvni strdki v obrobnem ožilju v okončinah.
Indikator rakavih bolezni
Najnovejše raziskave kažejo, da je lahko trombocitoza veliko bolj nevarna, kot se je predvidevalo do sedaj.
Študija, objavljena na spletni strani mednarodne publikacije IBM razkriva, da je lahko povečano število trombocitov v nekaterih primerih celo zunanji pokazatelj raka.
Glede na študijo, pri približno tretjini bolnikov s trombombocitozo, ki so imeli pljučnega raka ali raka debelega črevesa, niso odkrili drugih simptom raka, kar bi lahko pomenilo, da so znanstveniki po tridesetih letih odkrili novi indikator oziroma zelo pomembni pokazatelj raka.
Študija, ki je objavljena na spletni strani sciencedaily.com navaja, da so britanski znanstveniki preučili zdravstveno dokumentacijo 40.000 bolnikov.
Pomembno pri zgodnjem odkrivanju raka
Pri 11.tih odstotkih moških in šestih odstotkih žensk, starejših od štirideset let, bolnikih, ki so imeli veliko število trombocitov, so v enem letu odkrili raka. Število se je povečalo, če je imela oseba še drugič v šestih mesecih zvišano število trombocitov. "Vemo, da je ključ do zdravljenja pravočasno postavljena diagnoza. Naša raziskava je pokazala, da je raka mogoče diagnosticirati tri mesece prej in to zaradi trombocitoze, kar je zelo pomembna in velika razlika," pravi avtorica študije Sarah Bailey.
dezurni@zurnal24.si

kaj pol leta ,tudi tri leta čakaš
Kaj ti pomaga tri mesece prej če čakaš specialista pol leta pa še potem ni rečeno da bo kaj iz preiskave
Najbolj žalostno pri tem pa je da zdravniki ne bodo tega jemali kot bolezen ozr. bodo spregledali in se odločili za druge vrste zdravljenja.